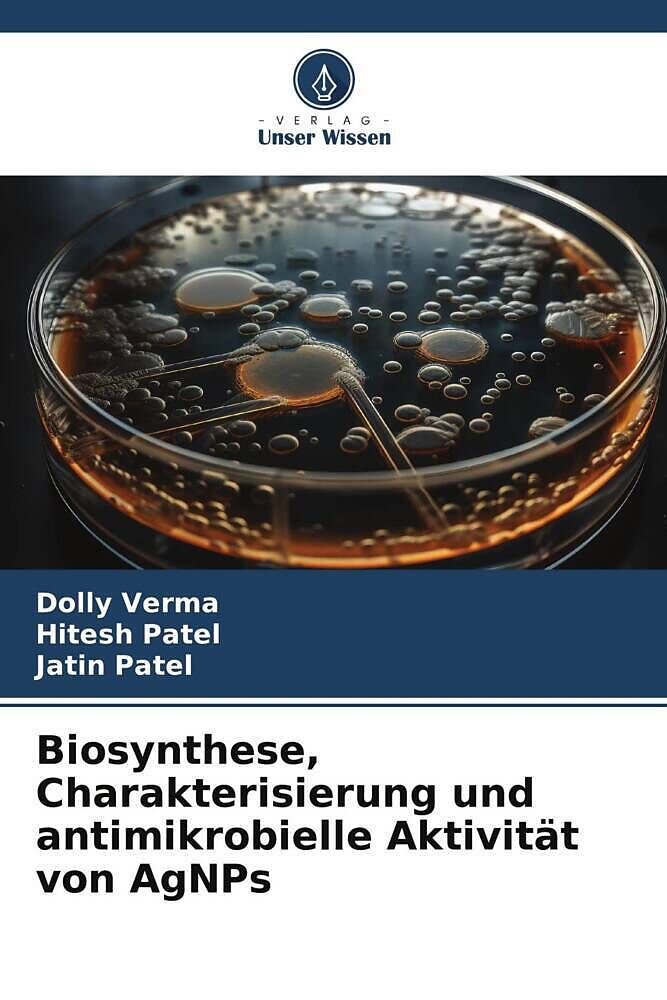
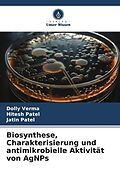

Beschreibung
In dieser Studie konzentrierten sich die Forscher auf die Auswahl der Pflanzen Bambusa Arundinaceae (Bambus) und Euphorbia Hirta für die Synthese von Silber-Nanopartikeln (AgNPs). Diese Pflanzen wurden aufgrund ihrer vielfältigen medizinischen Eigenschaften au...